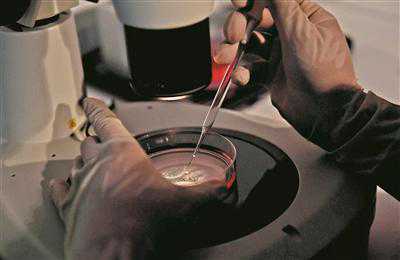

您现在的位置是:首页 > 试管指南
绝处逢希望 试管孕新生
试管快通站
2024-11-16【试管指南】67人已围观
简介在超声引导下,从卵巢内取出卵泡液和卵子①取卵②捡卵③受精准备④卵细胞浆单精子穿刺⑤胚胎“复苏”:从冷冻罐里取出胚胎⑥冻胚移植手术⑦怀孕四个月的阿莉返院产检,也顺便看看帮她怀孕的“橄榄绿好孕团队”。文、图/全媒体记者乔军伟来自贵州的阿莉,今年41岁,夫妻俩结婚十年,一直没有孩子,反复发生了4次自然流产...

在超声引导下,从卵巢内取出卵泡液和卵子

①取卵
②捡卵

③受精准备

④卵细胞浆单精子穿刺

⑤胚胎“复苏”:从冷冻罐里取出胚胎

⑥冻胚移植手术

⑦怀孕四个月的阿莉返院产检,也顺便看看帮她怀孕的“橄榄绿好孕团队”。
文、图/全媒体记者乔军伟
来自贵州的阿莉,今年41岁,夫妻俩结婚十年,一直没有孩子,反复发生了4次自然流产,在外地做了4次试管婴儿也都失败了。今年大年初一,她来到了被称为“橄榄绿好孕团队”的武警广东省总队医院生殖中心寻求帮助。专家针对阿莉卵巢功能严重减退,多发性子宫肌瘤的情况,为她量身打造了一套方案。采用微刺激方案,终于取出了2枚卵子,通过实验室的精心培养,卵细胞成功受精,并被培育成两枚优质的胚胎。由于阿莉的子宫内膜情况暂时达不到标准,医生把胚胎全部冷冻起来。经过两个月的调理及内膜处理,阿莉的身体情况和内膜达标后,医生把胚胎放进了她的子宫,她这一次终于成功怀孕了。事实上,与阿莉的情况相似的求医者还有很多。随着二孩政策的实施,越来越多的大龄夫妻选择试管婴儿,团队每天都为这些求医者进行诊疗。据介绍,世界首例试管婴儿出生于1978年。30多年间,我国辅助生殖技术水平进入了全球第一阵营,试管婴儿技术从第一代发展到了第三代、第四代。如今,试管婴儿技术的研究发展,已经从解决“生不出”难题,转变为对“生得健康”的追求。想通过试管婴儿技术成功受孕,许多人还要面对高龄这个最大障碍。目前,在国内各大生殖中心,35岁以下做试管婴儿的成功率一般可达60%,甚至更高;但过了36岁,成功率以超过10%的数额逐年递减,40岁以上的低于20%。专家建议,如果有生育愿望而努力1至2年后未果的患者,应及时就医。做试管婴儿也要赶早,女方年龄一般不超42岁,36岁以下为佳。说起团队的工作,作为资深生殖专家的孔欣主任说:“辅助生殖技术固然在老百姓心中有点神秘,但其实是今天比较成熟的一项技术。阿莉反复流产、反复试管婴儿失败后在我们这里助孕成功,并不是因为我们比别人有更加高超的技术,而是我们的责任心和认真态度!”凭着这种工作态度,他们让许多求孕者少走了弯路,圆了多年的梦想。
很赞哦!(139)
上一篇:孕期压力大会怎么样
下一篇:试管婴儿可以选择性别吗